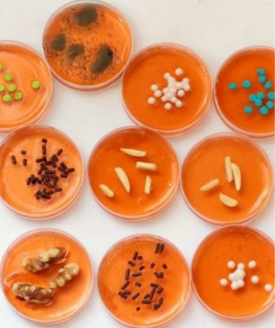

Category
Location
Event Date
-
Recreate your favorite bacteria with candy and other snacks! Reference photos and all other materials will be provided.
No required registration.
For ages 11-18.
For more details, please email us at FFLteens@burlingtonvt.gov or call us at 802.540.2546.